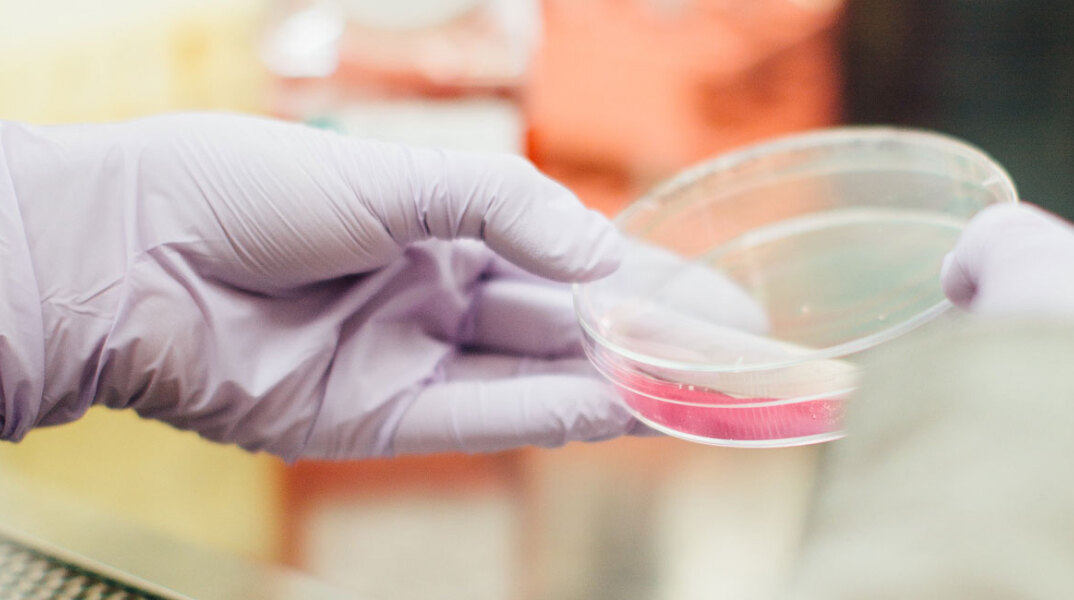
doc.jpg

- CITY GUIDE
- PODCAST
-
 17°
17°

Μία σπουδαία ανακάλυψη έφεραν στο φως ερευνητές στην έρημο της Σαχάρας στη Μαυριτανία της δυτικής Αφρικής, ανακαλύπτωντας το αρχαιότερο χρώμα στον κόσμο.
Όπως αναφέρει ο Guardian, υπέυθυνη της ανακάλυψης είναι η διδακτορική φοιτήτρια Dr. Nur Gueneli, η οποία ανέφερε ότι το αρχαιότερο χρώμα στον κόσμο είναι το λαμπερό ροζ, που θυμίζει τσιχλόφουσκα.
Αυτό μάλιστα είναι πάνω από 500 χρόνια παλαιότερο από τα επόμενα παλαιότερα γνωστά χρώματα και η ηλικία του φτάνει τα 1,1 δισ. χρόνια.
«Τα λαμπερά ροζ χρώματα είναι τα μοριακά απολιθώματα της χλωροφύλλης που παρήγαγαν αρχαίοι συνθετικοί οργανισμοί που κατοικούσαν σε έναν αρχαίο ωκεανό που έχει εξαφανιστεί εδώ και πολύ, πολύ καιρό» δήλωσε η Dr. Gueneli σε ένα δελτίο Τύπου.
«Φυσικά θα μπορούσατε να πείτε ότι τα πάντα έχουν κάποιο χρώμα», δήλωσε η ερευνήτρια Jochen Brocks από το Εθνικό Πανεπιστήμιο της Αυστραλίας, που έκανε την έρευνα. «Αυτό που βρήκαμε είναι το παλαιότερο βιολογικό χρώμα».
Για να ανακαλύψουν τις χρωστικές ουσίες, οι ερευνητές συνέθλιψαν τους βράχους των δισεκατομμυρίων ετών σε σκόνη και εξήγαγαν και ανέλυσαν τα μόρια των αρχαίων οργανισμών μέσα τους.
Όταν αραιώθηκαν, οι αρχικές χρωστικές είχαν έναν λαμπερό ροζ χρώμα. Στην αντίθετη περίπτωση τα απολιθώματα μπορούν να κυμανθούν από ένα κόκκινο του αίματος μέχρι ένα βαθύ μοβ.
Η έρευνα, υποστηριζόμενη από την Geoscience Australia, ήταν υπό την ηγεσία της ANU και διεξήχθη με επιστήμονες από τις ΗΠΑ και την Ιαπωνία.
ΤΑ ΠΙΟ ΔΗΜΟΦΙΛΗ

ΔΙΑΒΑΖΟΝΤΑΙ ΠΑΝΤΑ
ΔΕΙΤΕ ΕΠΙΣΗΣ
Tι δήλωσε ο επίτροπος για τον αποκλεισμό του Ορμούζ
Οι κυβερνήσεις συμβουλεύουν τους πληγέντες να ακυρώσουν και να αντικαταστήσουν τα διαβατήριά τους
Κάλεσε επίσης την Ουάσινγκτον να κάνει περισσότερα για να τερματίσει τον πόλεμο
Ενώ αντιμετωπίζει κατηγορίες για βιασμό και σεξουαλική επίθεση
Η πρώτη επίσκεψη Γάλλου προέδρου στη Μεγαλόνησο από το 1960
Η αποχώρηση των σοσιαλδημοκρατών αφήνει χωρίς πλειοψηφία τη κυβέρνηση, σε κίνδυνο τα κονδύλια της ΕΕ
Οι γυναίκες της χώρας της νοτιονατολικής Ασίας είναι εκτεθειμένες σε ασθένειες, πόνο και σεξισμό
Το εύρημα εντοπίστηκε στο λεγόμενο Δυτικό Θέατρο το οποίο φέρεται να λειτουργούσε ως πολιτιστικός φάρος
Ο επιστήμονας εργαζόταν σε προγράμματα πυρηνικής προώθησης
Οι εκκλήσεις προς τους παγκόσμιους ηγέτες να αυξήσουν τη φορολογία των υπερπλουσίων αυξάνονται
Μάρτυρες περιγράφουν έντονη αναστάτωση, με φωνές και διαμαρτυρίες
Η ανάρτηση στο Truth Social
Tα περισσότερα γυρίσματα για τα διάσημα Mac γίνονται εδώ
Φόβοι ότι η επισιτιστική ανασφάλεια θα κορυφωθεί σε μερικούς μήνες
«Το πλοίο μετέφερε πετρέλαιο από το Ιράν», ισχυρίζεται η Ουάσιγκτον
Νεκρή η μητέρα και τα δύο παιδιά - Νοσηλεύεται σε κρίσιμη κατάσταση η μεγαλύτερη κόρη
Ο γιος του Σάχη επικρίνει τη γερμανική κυβέρνηση επειδή αρνήθηκε να τον συναντήσει
Ποιες εναλλακτικές διαδρομές υπάρχουν και πόσο αποτελεσματικές είναι
Η αγωγή της Lorrayne Mavromatis κάνει λόγο για κάθε μορφή παρενόχλησης μέχρι εξοντώσεώς της
Έχετε δει 20 από 200 άρθρα.






















































